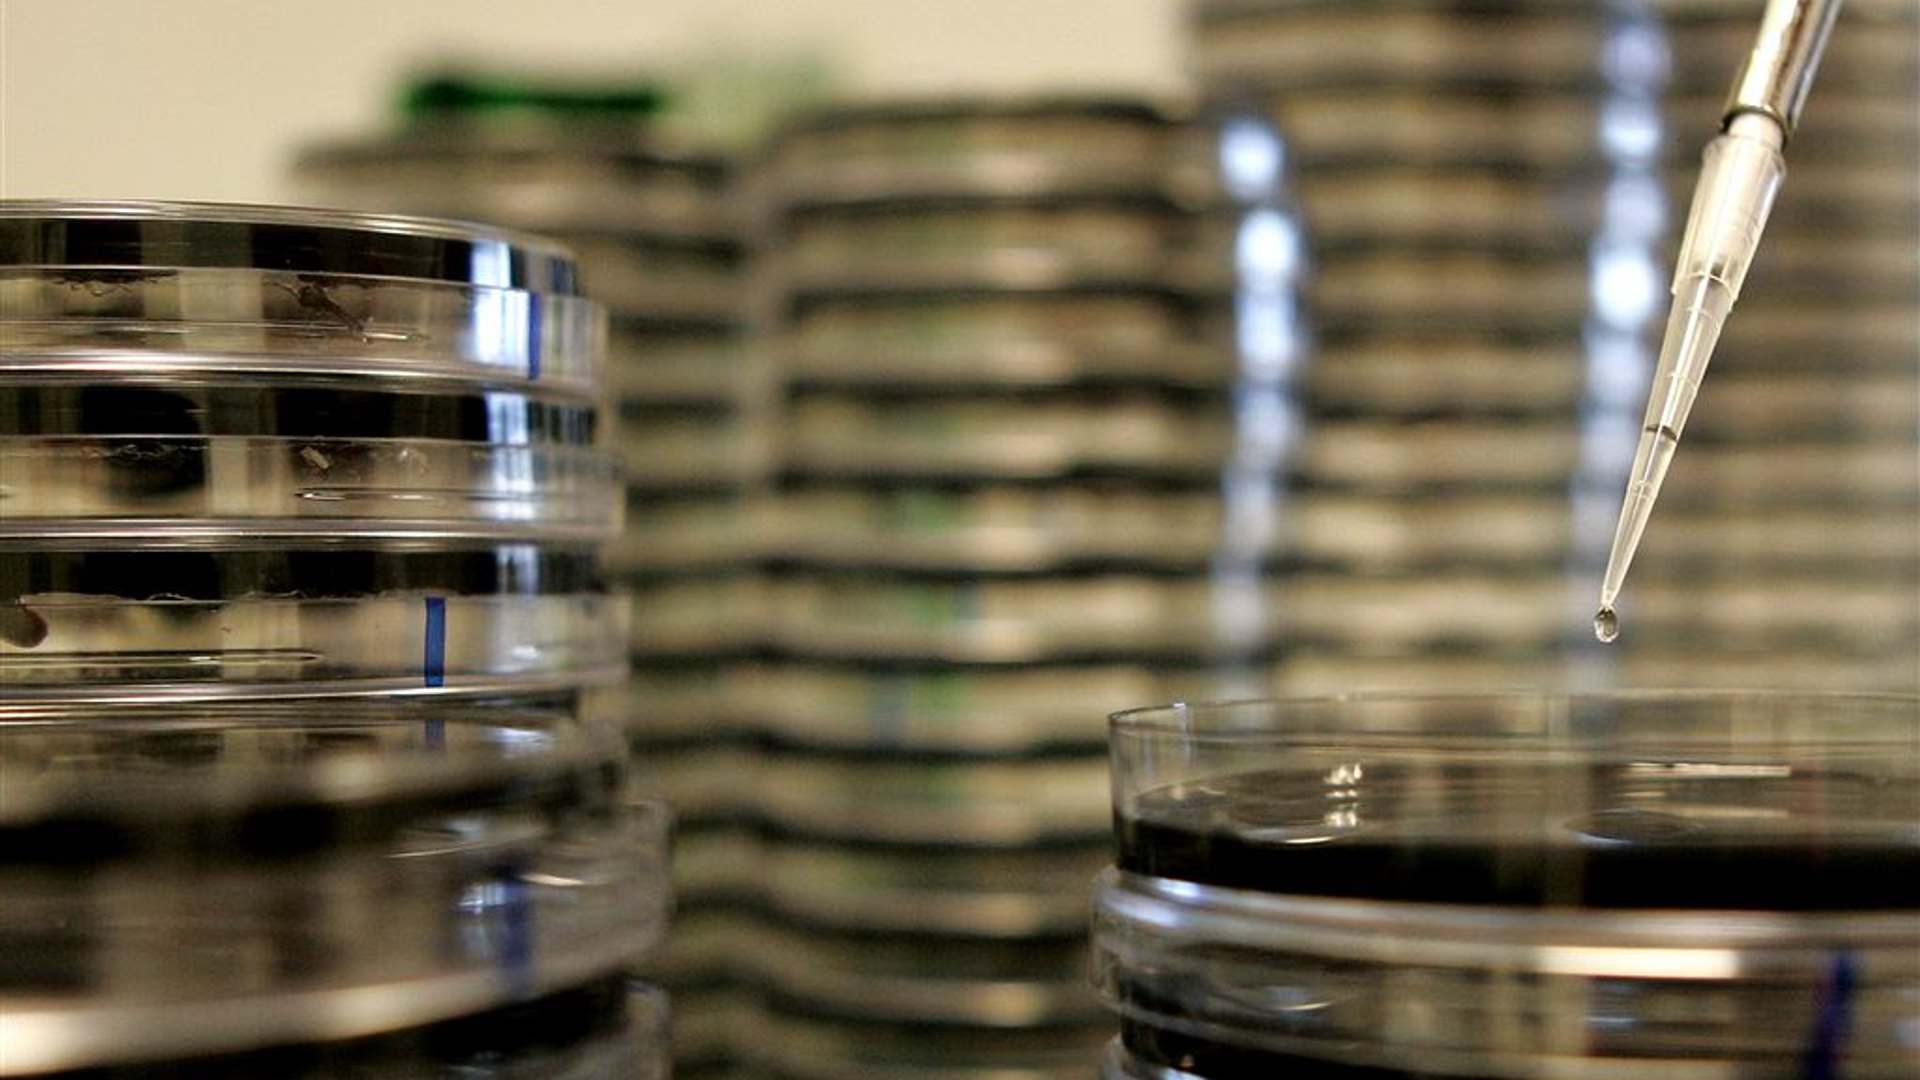
legionella anp

Zembla is het onderzoeksjournalistieke platform van BNNVARA.
GGD miste informatie die legionellaslachtoffers had kunnen voorkomen
29-09-2018
•leestijd 4 minuten
•187 keer bekeken
•
Er is internationaal-wetenschappelijke informatie voorhanden die verspreiding van de legionellabacterie bij waterzuiveringsinstallaties in Son en Boxtel had kunnen voorkomen. Die informatie zagen de GGD’s Hart voor Brabant en Brabant-Zuidoost tijdens het bronnenonderzoek over het hoofd, blijkt uit onderzoek van ZEMBLA. In totaal raakten de afgelopen jaren in de omgeving van de installaties in Son en Boxtel zeker 22 mensen besmet.
“Tot op heden staan dit soort bedrijven niet op onze lijst van waar je (bij legionella, red.) aan moet denken. Ik wist niet dat het rechtstreeks vanuit zo’n bassin in de lucht komt en een risico vormt voor de omgeving", zegt infectiearts Ronald Ter Schegget van de GGD Brabant-Zuidoost.
Eerste besmettingen in 2013
In Son vonden de eerste besmettingen in 2013 plaats en in Boxtel in 2016. De waterzuiveringsinstallatie van vleesverwerker Vion in Boxtel werd in december 2017 als oorzaak aangewezen. Bij de installatie van destructiebedrijf Rendac in Son gebeurde dit pas in maart 2018. Eén van de patiënten uit Son overleed aan de gevolgen van de legionellabesmetting.
In Son vonden de eerste besmettingen in 2013 plaats en in Boxtel in 2016. De waterzuiveringsinstallatie van vleesverwerker Vion in Boxtel werd in december 2017 als oorzaak aangewezen. Bij de installatie van destructiebedrijf Rendac in Son gebeurde dit pas in maart 2018. Eén van de patiënten uit Son overleed aan de gevolgen van de legionellabesmetting.
Navraag door ZEMBLA bij de Australische professor Faisal Hai, verbonden aan de Universiteit van Wollongong en expert op het gebied van milieutechniek, leert dat waterzuiveringsinstallaties al langer bekend zijn als bronnen van legionella. Hij wijst onder meer op wetenschappelijke studies in Finland en Noorwegen uit 2010 over waterzuiveringsinstallaties van waaruit legionella is verspreid.
'Nooit geweten'
Ondanks dat de internationale wetenschap afvalwaterzuiveringsinstallaties al langer beschouwt als mogelijke verspreidingsbron van legionella, zegt infectiearts Ronald Ter Schegget van de GGD Brabant-Zuidoost dit nooit te hebben geweten. Daarom werd de installatie van Rendac aanvankelijk niet meegenomen in het eerste onderzoek naar de bron van de besmettingen in de regio rond Son.
Ondanks dat de internationale wetenschap afvalwaterzuiveringsinstallaties al langer beschouwt als mogelijke verspreidingsbron van legionella, zegt infectiearts Ronald Ter Schegget van de GGD Brabant-Zuidoost dit nooit te hebben geweten. Daarom werd de installatie van Rendac aanvankelijk niet meegenomen in het eerste onderzoek naar de bron van de besmettingen in de regio rond Son.
Op de vraag of er minder legionellabesmettingen hadden plaatsgevonden als de waterzuiveringsinstallatie bij Rendac eerder als oorzaak was ontdekt, zegt infectiearts Ter Schegget: “Ja, natuurlijk. Als je het weet, dan doe je er wat aan. Als we morgen alle koeltorens uitzetten in Nederland hebben we ook minder besmettingen.”
Boxtel
De waterzuiveringsinstallatie in Boxtel bleef lang buiten zicht, omdat men dacht dat bij deze installatie water niet wordt verneveld. Toen de bron in Boxtel was ontdekt, schreef de GGD Hart voor Brabant in een persbericht, dat in dit zuiveringsproces ‘geen duidelijke waterdruppels’ worden gevormd. Besmetting van legionella vindt alleen via verneveling plaats, omdat de besmette waterdruppels dan kunnen worden ingeademd.
De waterzuiveringsinstallatie in Boxtel bleef lang buiten zicht, omdat men dacht dat bij deze installatie water niet wordt verneveld. Toen de bron in Boxtel was ontdekt, schreef de GGD Hart voor Brabant in een persbericht, dat in dit zuiveringsproces ‘geen duidelijke waterdruppels’ worden gevormd. Besmetting van legionella vindt alleen via verneveling plaats, omdat de besmette waterdruppels dan kunnen worden ingeademd.
Maar de internationaal-wetenschappelijke literatuur over waterzuiveringsinstallaties als bronnen van legionella stelt ook vast dat legionella zich vanuit die bronnen over de omgeving kan verspreiden. Infectiearts Christian Beulens van de GGD Hart voor Brabant: “Dat was hier (bij de waterzuivering van Vion, red.) minder duidelijk dan bij een koeltoren of een sproei-installatie.”
Volgens infectiearts Beulens was de kennis over de besmettingen in Finland en Noorwegen bij hem weliswaar bekend, maar week het verspreidingsgebied van de legionellabacterie in Boxtel daarvan af. Daarom bleef de waterzuiveringsinstallatie bij Vion lang uit beeld.
Boelens: “Op basis van de kennis uit ons onderzoek naar hoe deze uitbraak is verlopen, zou je natuurlijk een volgende keer de waterzuiveringsinstallatie wel meenemen om te testen”.
Zowel in Boxtel als in Son hebben de betrokken bedrijven inmiddels maatregelen getroffen om verdere verspreiding van legionella te voorkomen.
RIVM
Dat er minder slachtoffers zouden zijn gevallen door de legionellabesmetting als de bronnen in Boxtel en Son eerder waren ontdekt, noemt het RIVM in een reactie “wijsheid achteraf”. Het RIVM stelt dat de literatuur over het legionellarisico bij waterzuiveringen bij het instituut bekend was, maar dat die niet toepasbaar leek op de situatie in Boxtel vanwege het grote verspreidingsgebied van de legionellabesmetting daar.
Dat er minder slachtoffers zouden zijn gevallen door de legionellabesmetting als de bronnen in Boxtel en Son eerder waren ontdekt, noemt het RIVM in een reactie “wijsheid achteraf”. Het RIVM stelt dat de literatuur over het legionellarisico bij waterzuiveringen bij het instituut bekend was, maar dat die niet toepasbaar leek op de situatie in Boxtel vanwege het grote verspreidingsgebied van de legionellabesmetting daar.
De informatie over de besmettingen vanuit waterzuiveringsinstallaties in Finland en Noorwegen wordt ook genoemd in een nieuw, gezamenlijk ‘uitbraakonderzoek’ van het Centrum voor Infectieziektenbestrijding van het RIVM en de GGD Hart voor Brabant.
De studie, ‘Two Community Clusters of Legionnaires’ Disease Directly Linked to a Biologic Wastewater Treatment Plant, the Netherlands’, is deze week gepubliceerd op de website van het Centers for Disease Control and Prevention (CDC). Het CDC is de Amerikaanse tegenhanger van het Rijksinstituut voor Volksgezondheid en Milieu (RIVM).
Meer besmettingen
Volgens infectiearts Ronald ter Schegget van de GGD-Brabant Zuidoost ligt het aantal besmettingen waarschijnlijk een stuk hoger. Maar omdat de identificatie van legionella bij een patiënt niet altijd mogelijk is, of omdat mensen eenvoudigweg niet ziek worden door de besmetting, zijn harde cijfers hierover onbekend
Volgens infectiearts Ronald ter Schegget van de GGD-Brabant Zuidoost ligt het aantal besmettingen waarschijnlijk een stuk hoger. Maar omdat de identificatie van legionella bij een patiënt niet altijd mogelijk is, of omdat mensen eenvoudigweg niet ziek worden door de besmetting, zijn harde cijfers hierover onbekend
Niet alleen de onbekendheid met de waterzuiveringsinstallatie als besmettingsbron, maar ook de geografische verspreiding van de besmettingsgevallen heeft het opsporen van de bron bemoeilijkt, zegt Ter Schegget.
Volg ZEMBLA ook op LinkedIn
Volg ZEMBLA ook op LinkedIn
Meer over:
legionella